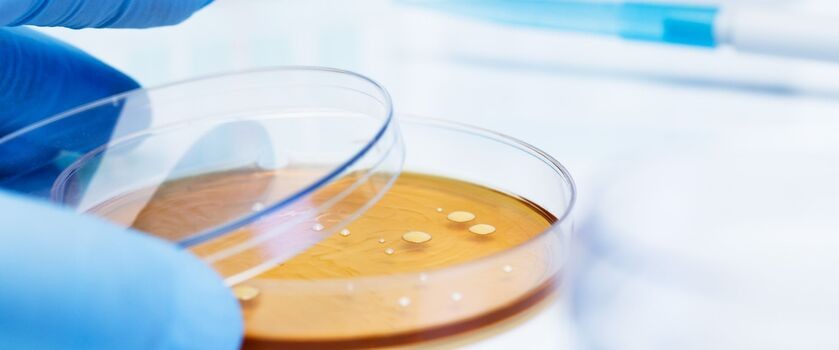

„Ukryte” bakterie jelitowe odpowiadają za zdrowie? Przełomowe badanie może zmienić podejście do probiotykoterapii
Przełomowe badanie międzynarodowego zespołu naukowego pokazuje, że w ludzkich jelitach funkcjonuje ogromna, dotąd niedostatecznie poznana grupa mikroorganizmów, która może mieć kluczowe znaczenie dla zdrowia. Tak zwane „ukryte” bakterie jelitowe – w szczególności linia CAG-170 – występują w znacznie większej liczbie u osób bez chorób przewlekłych. Odkrycie to sugeruje, że bakterie te mogą stanowić zarówno marker zdrowego mikrobiomu, jak i potencjalny cel przyszłych terapii probiotycznych.
- „Ukryty mikrobiom” – nowe spojrzenie na zdrowie jelit
- Bakterie CAG-170 – czym są i jaką pełnią rolę?
- Znaczenie odkrycia dla zdrowia i farmacji
- Najnowsze badania nad mikrobiomem jelitowym – najczęściej zadawane pytania
Z tego artykułu dowiesz się:
- czym są niehodowlane bakterie jelitowe i dlaczego przez lata pozostawały poza głównym nurtem badań,
- w jaki sposób obecność bakterii z linii CAG-170 wiąże się z odpornością i zdrowiem metabolicznym,
- jak najnowsze odkrycia mogą zmienić podejście do diagnostyki mikrobiomu i rozwoju probiotyków.
Dzięki temu artykułowi dowiesz się, dlaczego lepsze zrozumienie tej dotąd pomijanej części mikrobiomu może realnie wpłynąć na profilaktykę i leczenie wielu chorób przewlekłych.
„Ukryty mikrobiom” – nowe spojrzenie na zdrowie jelit
Jelita są siedliskiem bilionów bakterii tworzących mikrobiom, czyli złożony ekosystem, który wpływa nie tylko na trawienie, ale również na metabolizm, funkcjonowanie układu odpornościowego, a nawet pracę mózgu poprzez tzw. oś mózg-jelita. Przez lata wiedza na temat mikrobiomu była jednak niepełna. W dużym uproszczeniu – znaczna część bakterii jelitowych pozostawała poza zasięgiem klasycznych badań, ponieważ nie można było analizować ich metodami mikrobiologicznymi opartymi na hodowli. Oznacza to, że choć mikroorganizmy te realnie funkcjonowały w jelitach, nie były uwzględniane w większości wcześniejszych analiz.
Przełom przyniosły nowoczesne techniki metagenomiczne. W badaniu opublikowanym w czasopiśmie „Cell Host & Microbe” naukowcy przeanalizowali ponad 11 000 próbek mikrobiomu pochodzących z 39 krajów. Badanie objęło zarówno osoby zdrowe, jak i pacjentów z 13 różnymi chorobami przewlekłymi i niezakaźnymi, w tym z zapalnymi chorobami jelit, otyłością czy zespołem przewlekłego zmęczenia. Analiza tych danych ujawniła wyraźny wzorzec – u osób zdrowych badana grupa bakterii z linii CAG-170 była znacznie liczniejsza i bardziej zróżnicowana niż u osób przewlekle chorych.
Bakterie CAG-170 – czym są i jaką pełnią rolę?
CAG-170 to grupa bakterii znana naukowcom głównie na podstawie materiału genetycznego. Większości z nich nie udało się dotąd wyizolować i utrzymać w warunkach laboratoryjnych, dlatego ich obecność była przez lata pomijana w badaniach opartych na klasycznej mikrobiologii. Dzięki analizie metagenomicznej – polegającej na sekwencjonowaniu DNA bez konieczności hodowli bakterii – badacze mogli nie tylko je zidentyfikować, ale również przewidzieć ich funkcje biologiczne.
Najważniejsze wnioski płynące z badania:
- obecność CAG-170 jest wyraźnie wyższa u osób zdrowych, niezależnie od regionu świata, który zamieszkuje dana osoba;
- u pacjentów z chorobami przewlekłymi obserwuje się istotnie niższy poziom tych bakterii, co wpisuje się w obraz dysbiozy jelitowej (zaburzenie równowagi mikrobiomu, które towarzyszy wielu chorobom przewlekłym);
- bakterie z tej linii wykazują zdolność do produkcji witaminy B12 (badacze twierdzą, że wspiera ona inne bakterie jelitowe i pomaga utrzymać stabilność całego ekosystemu jelit) oraz enzymów rozkładających węglowodany i błonnik;
- ich aktywność może pośrednio wspomagać funkcjonowanie innych korzystnych drobnoustrojów jelitowych.
Zebrane dane sugerują, że CAG-170 mogą pełnić rolę „organizatora” zdrowego mikrobiomu jelitowego – wspierają jednocześnie stabilność całego ekosystemu jelit, ale także pojedyncze procesy trawienne.
Znaczenie odkrycia dla zdrowia i farmacji
Odkrycie „ukrytych” bakterii jelitowych może mieć istotne konsekwencje praktyczne.
- Nowe wskaźniki zdrowia jelit
Dotychczas ocena mikrobiomu koncentrowała się głównie na dobrze znanych rodzajach bakterii takich jak Bifidobacterium czy Lactobacillus. Tymczasem nowe dane wskazują, że obecność CAG-170 może lepiej odzwierciedlać rzeczywisty stan zdrowia mikrobioty oraz odporności metabolicznej organizmu.
|
|
|
- Probiotyki nowej generacji
Współczesne probiotyki bazują na wąskiej grupie stosunkowo łatwych do hodowli szczepów. Wyniki badań sugerują jednak, że przyszłe terapie mogą skupiać się na wspieraniu rozwoju trudniej dostępnych, ale biologicznie kluczowych bakterii. Takie podejści może zwiększyć skuteczność leczenia dysbiozy jelitowej.
- Choroby przewlekłe a mikrobiom
Niski poziom CAG-170 obserwowano u osób z wieloma chorobami cywilizacyjnymi. Choć zależność ta nie dowodzi jeszcze bezpośredniego związku przyczynowego, otwiera nowe kierunki badań nad rolą mikrobiomu w chorobach metabolicznych, immunologicznych i neurologicznych.
Nowe badanie rzuca światło na dotąd niewidoczny aspekt ludzkiej mikrobioty. Niehodowlane bakterie jelitowe, z linią CAG-170 na czele, wydają się silnie powiązane z dobrym zdrowiem i równowagą mikrobiomu, co czyni je jednym z najciekawszych obszarów współczesnych badań nad jelitami.
Najnowsze badania nad mikrobiomem jelitowym – najczęściej zadawane pytania
Czy obecność CAG-170 można już sprawdzić w badaniach mikrobiomu?
Obecnie standardowe testy mikrobiomu rzadko uwzględniają tę grupę bakterii. Ich analiza wymaga zaawansowanych metod metagenomicznych, które dopiero stopniowo wchodzą do praktyki klinicznej.
Czy dieta może wpływać na rozwój niehodowlanych bakterii jelitowych?
Choć potrzebne są dalsze badania, naukowcy przypuszczają, że dieta bogata w błonnik i różne składniki odżywcze sprzyja większej różnorodności mikrobiomu, co może pośrednio wspierać także bakterie z linii CAG-170.


 Strefa okazji
Strefa okazji
 Nowości
Nowości
 Krótkie daty
Krótkie daty





























